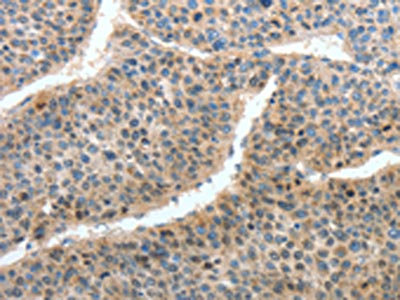

HTR3A Antibody
-
中文名稱:HTR3A兔多克隆抗體
-
貨號:CSB-PA107614
-
規格:¥1100
-
圖片:
-
The image on the left is immunohistochemistry of paraffin-embedded Human liver cancer tissue using CSB-PA107614(HTR3A Antibody) at dilution 1/35, on the right is treated with fusion protein. (Original magnification: ×200)
-
Gel: 10%SDS-PAGE, Lysate: 40 μg, Lane: Mouse intestinum tenue tissue, Primary antibody: CSB-PA107614(HTR3A Antibody) at dilution 1/375, Secondary antibody: Goat anti rabbit IgG at 1/8000 dilution, Exposure time: 1 minute
-
-
其他:
產品詳情
-
Uniprot No.:
-
基因名:
-
別名:HTR3A; 5HT3R; HTR3; 5-hydroxytryptamine receptor 3A; 5-HT3-A; 5-HT3A; 5-hydroxytryptamine receptor 3; 5-HT-3; 5-HT3R; Serotonin receptor 3A; Serotonin-gated ion channel receptor
-
宿主:Rabbit
-
反應種屬:Human,Mouse,Rat
-
免疫原:Fusion protein of Human HTR3A
-
免疫原種屬:Homo sapiens (Human)
-
標記方式:Non-conjugated
-
抗體亞型:IgG
-
純化方式:Antigen affinity purification
-
濃度:It differs from different batches. Please contact us to confirm it.
-
保存緩沖液:-20°C, pH7.4 PBS, 0.05% NaN3, 40% Glycerol
-
產品提供形式:Liquid
-
應用范圍:ELISA,WB,IHC
-
推薦稀釋比:
Application Recommended Dilution ELISA 1:1000-1:2000 WB 1:200-1:1000 IHC 1:25-1:100 -
Protocols:
-
儲存條件:Upon receipt, store at -20°C or -80°C. Avoid repeated freeze.
-
貨期:Basically, we can dispatch the products out in 1-3 working days after receiving your orders. Delivery time maybe differs from different purchasing way or location, please kindly consult your local distributors for specific delivery time.
-
用途:For Research Use Only. Not for use in diagnostic or therapeutic procedures.
相關產品
靶點詳情
-
功能:This is one of the several different receptors for 5-hydroxytryptamine (serotonin), a biogenic hormone that functions as a neurotransmitter, a hormone, and a mitogen. This receptor is a ligand-gated ion channel, which when activated causes fast, depolarizing responses in neurons. It is a cation-specific, but otherwise relatively nonselective, ion channel.
-
基因功能參考文獻:
- This study demonstrated that the C and E subunits when assembled as simple or complex heteromeric 5-HT3 receptors may alter efficacies of serotonin and clinically used antagonists. PMID: 29793334
- Methylation status of the HTR3A gene in mothers is linked to maternal violence-related psychopathology, trauma-induced brain activation patterns, and child attachment disturbance during a sensitive period in the development of self-regulation. PMID: 27720744
- This study did not found HTR3A play a major role in predicting Antipsychotic-Induced Weight Gain. PMID: 28531893
- Methylation pattern changes in the 5-HTR3A gene were associated with suicidal behavior in borderline personality disorder, bipolar disorder, and attention deficit/hyperactivity disorder (ADHD). PMID: 28470485
- findings suggest that HTR3A mRNA expression levels were positively correlated with craving in Han Chinese alcohol-dependent patients. PMID: 27144979
- Study provides structural data showing the orientation of palonosetron in a 5-HT3 receptor binding site mimic, combined with functional data in the 5-HT3 receptor, provide an explanation for the high affinity and long-lived actions of this compound. These are likely due to specific interactions formed with binding site residues, and its location as a tight and effective wedge in the binding pocket. PMID: 27656911
- Studies have demonstrated that 5-HT3 receptors modulate the activity of vascular and non-vascular smooth muscles. PMID: 27720614
- The HTR3A rs1062613 polymorphisms do not seem to directly influence experimental muscle pain in healthy individuals. However, women reported higher pain intensity and larger pain area than men, which might partly be attributed to genotype. PMID: 28002447
- Studies with 16 arylguanidines found that their functional activity spanned a broad spectrum from superagonist to full agonist, partial agonist, and antagonist at 5-HT3 receptors; results confirm the utility of phenylguanidine as an extremely versatile scaffold in the design of 5-HT3 ligands with a "tunable" level of agonist or antagonist activity PMID: 27533595
- Analysis of our small Chinese sample revealed a significant association of HTR3A with bipolar disorder, but yielded no evidence of an association between HTR3B and bipolar disorder. Furthermore, evidence for an association was found for a haplotype of HTR3A. PMID: 27706728
- Serotonin 3A receptor (5-HT3AR) is associated at the genetic and epigenetic levels with a variety of psychiatric disorders. PMID: 26350166
- A gene-environment interaction is revealed between childhood trauma and 5-htr3a polymorphisms. PMID: 26701104
- 5-HT3A receptor distal targeting in axons and dendrites depends on P2X2R expression. PMID: 26843630
- Agonist- and antagonist-induced up-regulation of surface 5-HT3 A receptors PMID: 25989383
- Data indicate that no two n-alkanols act alike, their spectra of effects on serotonin receptor 3A (5-HT3A) receptors differ. PMID: 25863270
- Our findings support the notion that different haplotypes of HTR3A have reciprocal effects in the etiology of Postoperative nausea. PMID: 25339231
- HTR3A gene variants may contribute to variability in severity of and response to antiemetic therapy for nausea and vomiting of pregnancy. PMID: 23786674
- These data support a role for intracellular salt bridges in maintaining the quaternary structure of the 5-HT3 receptor and suggest a role for the intracellular domain in allosteric modulation of cooperativity and agonist efficacy. PMID: 24283776
- To conclude, considering 5-hydroxytryptamine 3A subtype receptor role in accomplishment of asthma symptoms, this increase in its expression may exacerbate the seriousness of asthma disease. PMID: 24338226
- Data suggest that HTR3A/HTR3B subunits readily form functionally distinct heteromeric receptors; molecular models have been developed regarding affinities of competitive ligands, non-competitive antagonists, and allosteric modulators. [REVIEW] PMID: 23489111
- A significant increase in the relative expression level of 5-HT(3A) receptor in PBMCs. PMID: 24304330
- variants in HTR3A, HTR3B, and SLC6A4 interactively contribute to etiology of alcohol, cocaine, and nicotine dependence PMID: 24590108
- the stoichiometry of 5-HT3AB receptors on the plasma membrane PMID: 23972841
- HTR3A, HTR3B, and SLC6A4 have significant interactions among their genes and are highly involved in nicotine dependence. PMID: 23290502
- Mutagenic analysis of the intracellular portals of the human 5-HT3A receptor. PMID: 24030822
- Genetic variability within SLC6A4, HTR3A, and HTR3B contributes to the risk of alcohol dependence and related phenotypes. PMID: 23757001
- Data indicate that Arg-436 is critical for the inward rectification of 5-HT3A receptor-mediated macroscopic currents. PMID: 23740249
- Polymorphisms in the HTR3A gene are predictors of reduced alcohol drinking in response to ondansetron. PMID: 23897038
- The findings of the present study do not support the involvement of the 5-HTR3A gene C178T polymorphism in tardive dyskinesia in Korean schizophrenia subjects. PMID: 23126479
- The association between HTR3A gene SNP and response to clozapine is influenced by various clinical predictors and by differing outcome definitions in patients with treatment-resistant schizophrenia. PMID: 22700043
- HTR3A and HTR3B were detected in all investigated brain tissues with the exception of the cerebellum, and large differences in the A:B subunit ratio were observed. PMID: 22832903
- Thus, rather than involving the 5-HT3-dependent pathway, the negative effect of ondansetron on platelet aggregation is instead manifested through the attenuation of agonist-induced IP3 production and MAPK (p38 and ERK2). PMID: 22818390
- This study does not support the hypothesis that the 5-HT(3A) receptor plays a major role in the pathogenesis of schizophrenia. PMID: 22328445
- CC genotype of TPH2 rs2171363, GG genotype of TPH2 rs7305115, CC genotype of HTR2A rs2770304, and CC genotype of HTR2A rs6313 were associated with reduced internalizing scores for children born in the quartile above the birth weightmidpoint. PMID: 21969281
- The serotonin receptor 3A c.-42T allele is associated with severe dyspeptic symptoms. The stronger association among dyspeptic patients carrying the serotonin transporter L allele suggests an additive effect of the two polymorphisms. PMID: 22014438
- Data show that 5-HTA/bungarotoxin binding sequence (BBS) receptors are constitutively internalized in the absence of an agonist and internalization as well as receptor function are inhibited by fluorescence. PMID: 21338684
- Report significant correlations of the HTR3A polymorphisms with amygdala responsiveness, anxiety, and irritable bowel syndrome symptom severity. PMID: 21420406
- Rings of charge within the extracellular vestibule influence ion permeation of the 5-HT3A receptor. PMID: 21454663
- findings indicate that HTR3A and HTR3B polymorphisms may not play a major role in the susceptibility to suicidal behavior in schizophrenia subjects. PMID: 21184810
- These findings suggest that the HTR3A CC genotype may be associated with alterations in brain structures central to emotion processing, particularly when exposed to stress. PMID: 20694966
- Six functional and coding variants of the subunit genes HTR3A, HTR3B as well as the novel HTR3C, HTR3D, and HTR3E subunits in the response to haloperidol or risperidone, were assessed. PMID: 19794330
- RIC-3 exclusively enhances the surface expression of human homomeric 5-hydroxytryptamine type 3A (5-HT3A) receptors despite direct interactions with 5-HT3A, -C, -D, and -E subunits. PMID: 20522555
- Evaluate HTR3A expression in normal and neoplastic B cells. PMID: 20516728
- variants in the HTR3A receptor gene can play a role in the treatment outcome of clozapine in schizophrenia patients that are refractory or intolerant of typical antipsychotic therapy PMID: 20168265
- 5-HT(3)A residue 312 and equivalent polar residues in the M3 of other Cys-loop subunits are essential determinants of homopentameric gating. PMID: 19933756
- the present investigation on transfected HEK293 cells revealed that Arg344His mutation of the h5-HT3A receptor, although not involved in genetic predisposition to schizophrenia, leads to a decreased density of the variant compared to wild type receptor PMID: 19904001
- These data provide direct evidence for an extracellular N-terminal domain and an intracellular loop between the third and fourth transmembrane domains, thus supporting the conventional ligand-gated ion channel subunit topological model. PMID: 12059035
- species-dependent gating mechanisms of 5-HT(3) receptors PMID: 12457738
- Cell surface expression of 5-hydroxytryptamine type 3 receptors is controlled by an endoplasmic reticulum retention signal PMID: 12750374
- 5HT3A receptor function and trafficking is regulated by protein kinase c through an F-actin-dependent mechanism PMID: 12791692
顯示更多
收起更多
-
亞細胞定位:Cell junction, synapse, postsynaptic cell membrane; Multi-pass membrane protein. Cell membrane; Multi-pass membrane protein.
-
蛋白家族:Ligand-gated ion channel (TC 1.A.9) family, 5-hydroxytryptamine receptor (TC 1.A.9.2) subfamily, HTR3A sub-subfamily
-
組織特異性:Expressed in cerebral cortex, amygdala, hippocampus, and testis. Detected in monocytes of the spleen and tonsil, in small and large intestine, uterus, prostate, ovary and placenta.
-
數據庫鏈接:
Most popular with customers
-
-
YWHAB Recombinant Monoclonal Antibody
Applications: ELISA, WB, IHC, IF, FC
Species Reactivity: Human, Mouse, Rat
-
Phospho-YAP1 (S127) Recombinant Monoclonal Antibody
Applications: ELISA, WB, IHC
Species Reactivity: Human
-
-
-
-
-